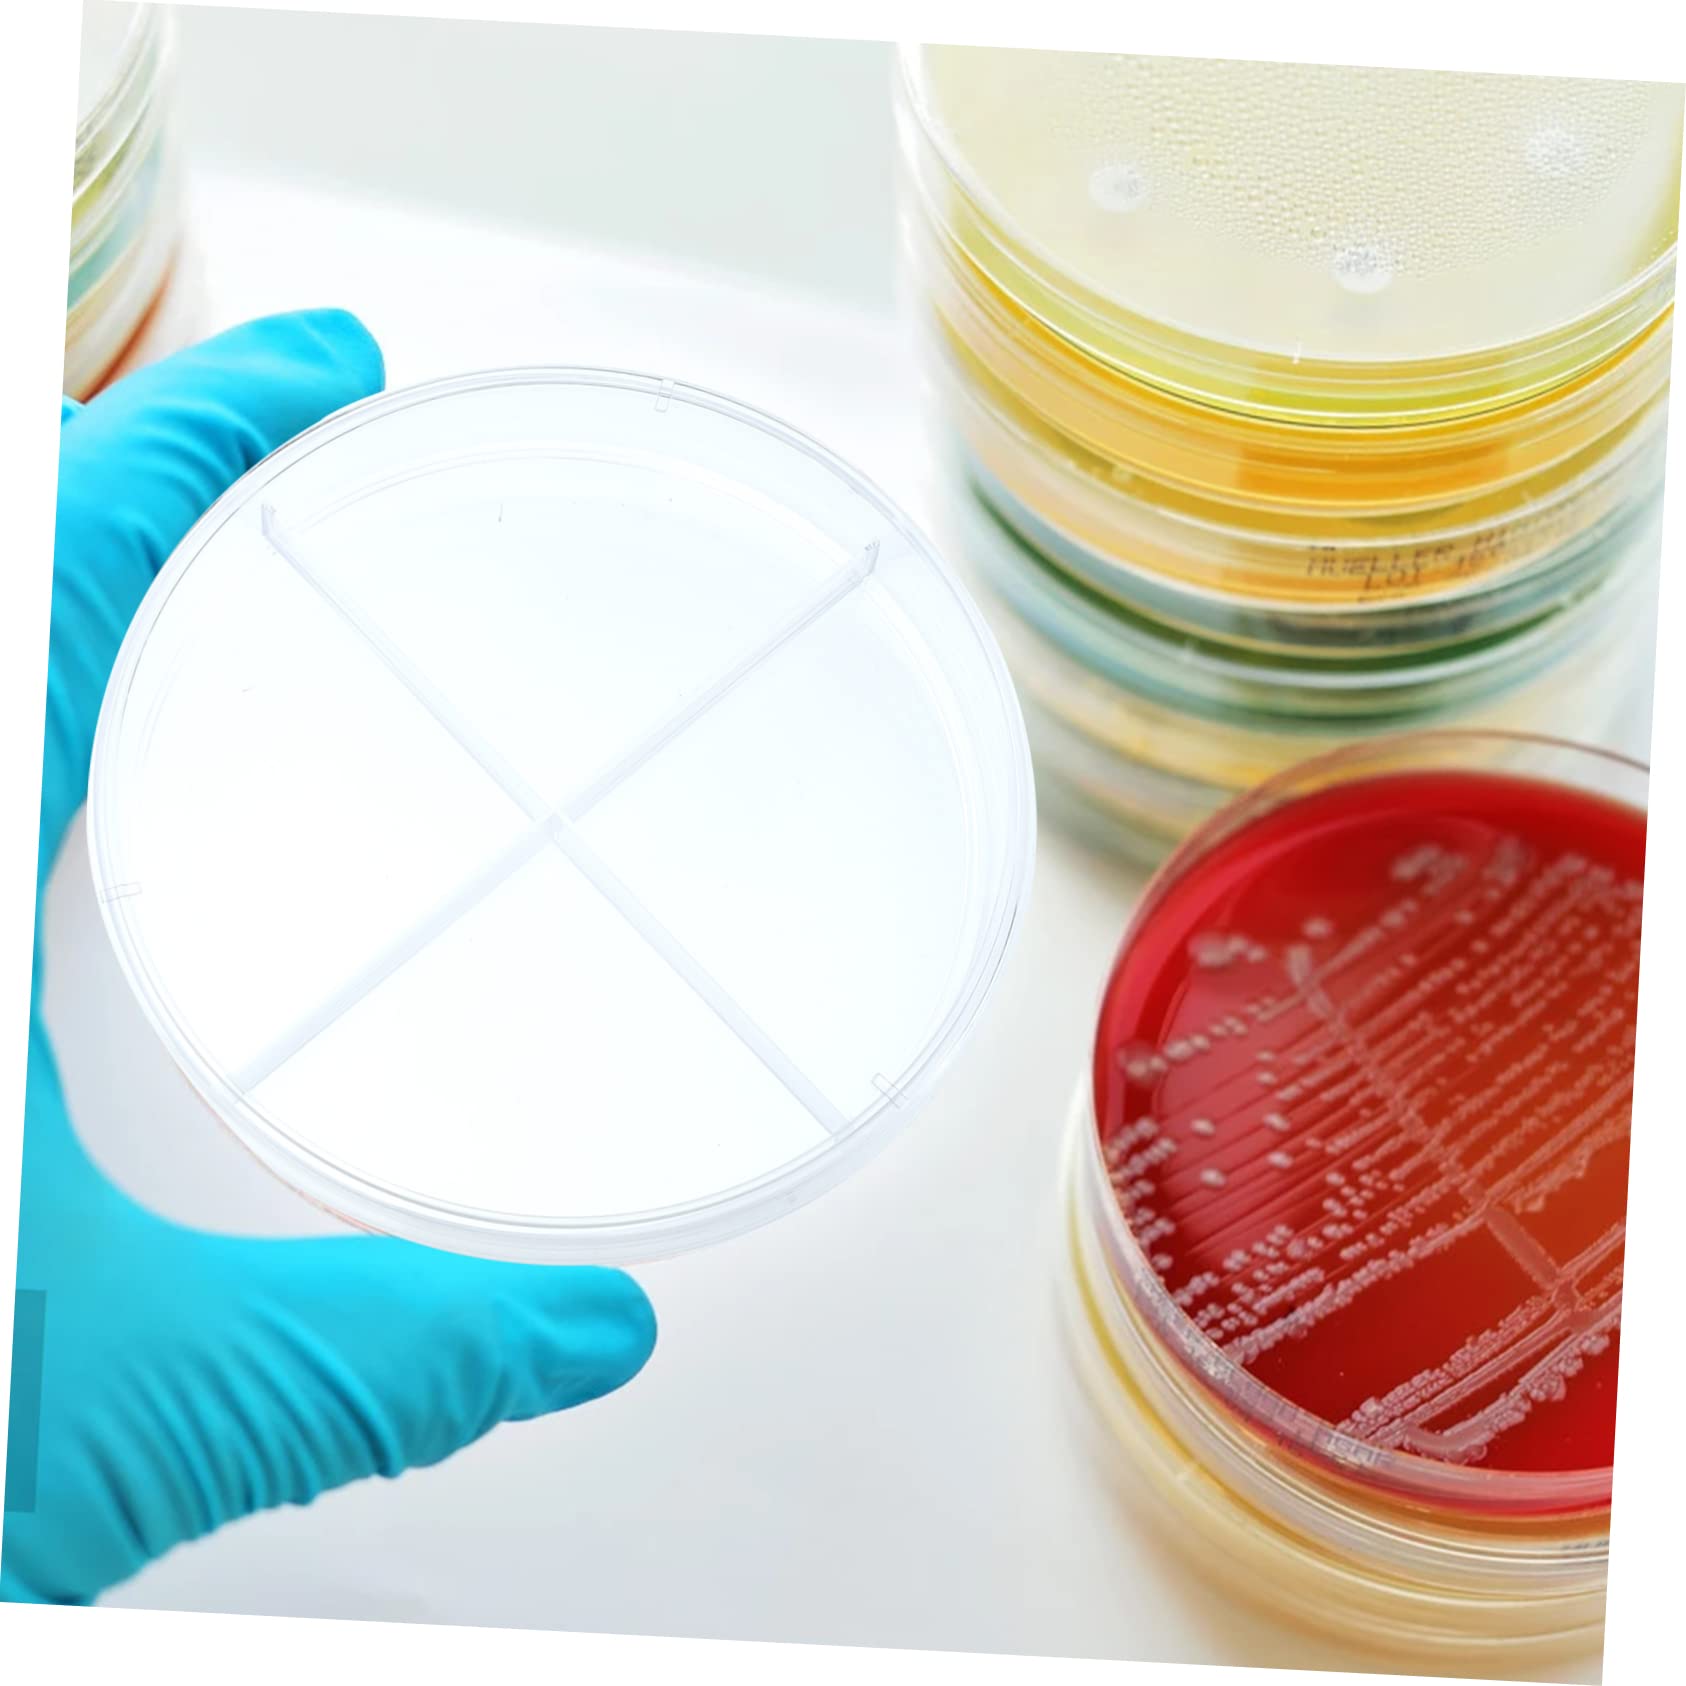
MUSISALY 10pcs Small Petri Dishes Cell Culture Dishes Lab Equipment Scientific Experiment Tool Cell Culture Flat

Product Information
Specification
Brand : MUSISALY
BulletPoint1 : Scientific experiment supplies-- this product set is experiments, biology, and microbiology research,teaching aid
BulletPoint2 : Culture plate-- professional and practical design with clear appearance, easy to convenient and use ,laboratory petri dish
BulletPoint3 : Plant supplies-- the clear petri easy to observe the changes of cell culture, and find more fun with your child,science petri dish
BulletPoint4 : Scientific teaching aid-- the cell culture petri easy and simple to use, excellent and reliable, bring much convenience to you.,lab tissue culture
BulletPoint5 : Clear petri dish-- the plastic cell culture petri dishes are excellent and and useful function, suitable for school use,cell- culture dishes
Color : Transparent Color
ItemDisplayDimensions_Length : 3.54 centimeters
ItemDisplayWeight : 0.29 pounds
ItemName : MUSISALY 10pcs Small Petri Dishes Cell Culture Dishes Lab Equipment Scientific Experiment Tool Cell Culture Flat
ItemPackageDimensions_Height : 4.72 inches
ItemPackageDimensions_Length : 5.91 inches
ItemPackageDimensions_Width : 4.72 inches
ItemTypeKeyword : science-lab-petri-dishes
ItemVolume : 1 cubic_centimeters
Manufacturer : MUSISALY
Material : plastic
ModelNumber : 1117119HX6PT
NumberOfItems : 1
NumberOfLithiumMetalCells : 1
PartNumber : 1117119HX6PT
ProductDescription : Package List
10 x petri dishes
Features
-Color: Transparent color laboratory.
-Material: Plastic cell culture.
-Size: About 9.00X9.00X1.50cm/3.54X3.54X0.59inch liner.
-The transparent design is very convenient for you to observe under the microscope and explore the mysteries of science teaxhing.
-The workmanship of this product is , and you will have a good experience in using it small.
-Not easily broken, the lid of the designed to be easy to cover and reduce pollution container.
-Easy to observe and the bottom of the flat and smooth without distortion, which makes the quantitative analysis more accurate Transparent Design Petri Dish.
-Made of high-class materials, and can be used for a long time culture.
Goods Description
Professional Petri Dish Our petri dishes are suitable for students or children to do experiments.Scientific Experiment Tool You can enjoy parent-child with children and explore the mysteries of science.laboratory plant cell dish Petri dishes can be stacked for easy storage and space saving
ProductSiteLaunchDate : 2024-10-12T10:06:24.538Z
Size : 9x9cm
SupplierDeclaredDgHzRegulation : not_applicable
UnspscCode : 52152000